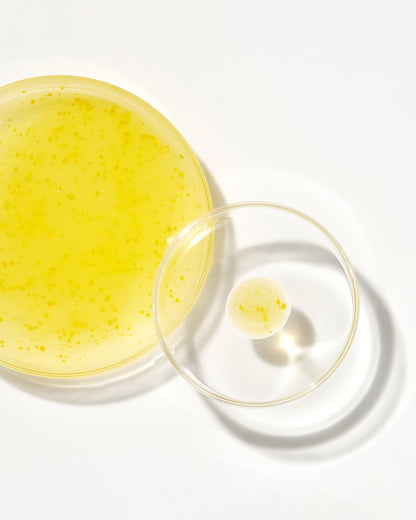

Votre panier est vide
Continuer les achatsVous possédez un compte ?
Connectez-vous pour payer plus vite.
Vous possédez un compte ?
Connectez-vous pour payer plus vite.
QUANTITÉ LIMITÉE !
✦ OCTOBRE ROSE : -50%
Livraison rapide
✦ OCTOBRE ROSE : -50%
Livraison rapide
✦ OCTOBRE ROSE : -50%
Livraison rapide
✦ OCTOBRE ROSE : -50%
Livraison rapide
✦ OCTOBRE ROSE : -50%
Livraison rapide
✦ OCTOBRE ROSE : -50%
Livraison rapide
✦ OCTOBRE ROSE : -50%
Livraison rapide
✦ OCTOBRE ROSE : -50%
Livraison rapide
✦ OCTOBRE ROSE : -50%
Livraison rapide
✦ OCTOBRE ROSE : -50%
Livraison rapide







 Peau visiblement rajeunie : réduit rides, taches et perte de fermeté pour un teint plus lisse et éclatant
Peau visiblement rajeunie : réduit rides, taches et perte de fermeté pour un teint plus lisse et éclatant
 Effet “peau neuve” instantané : affine le grain de peau, floute les imperfections et illumine le visage sans effet gras
Effet “peau neuve” instantané : affine le grain de peau, floute les imperfections et illumine le visage sans effet gras
 Résultats rapides & durables : amélioration visible dès 7 jours, transformation progressive sans irritation.
Résultats rapides & durables : amélioration visible dès 7 jours, transformation progressive sans irritation.
 Confort absolu : texture fluide et apaisante, qui hydrate intensément sans tiraillements ni picotements.
Confort absolu : texture fluide et apaisante, qui hydrate intensément sans tiraillements ni picotements.



Impossible de charger la disponibilité du service de retrait


Commande avant pour recevoir d'ici | 90 jours de retour garantie
La recette secrète de LUMINOR pour une peau jeune et rebondie ! Le sérum SEOUL 1988, grâce à sa formule à 2% de rétinol liposomé, pénètre les couches les plus profondes de la peau pour améliorer l'élasticité cutanée et lutter efficacement contre les ridules, taches brunes et imperfections du teint. Grâce aux extraits de ginseng noir, au bakuchiol, à la vitamine C et aux peptides, ce sérum viral regorge d'antioxydants et stimule la production de collagène, faisant de lui le soin anti-âge ultime adapté à tous types de peau, même matures.
Pour réduire les irritations, appliquez de la crème hydratante avant et après votre sérum, comme pour protéger le rétinal entre deux couches hydratantes.
Panax Ginseng Root Extract, Water, Glycerin, Dipropylene Glycol, Caprylic/ Capric Triglyceride, 1,2-Hexanediol, Niacinamide, Butylene Glycol, Methyl Gluceth-20, Polyglyce- ryl-3 Methylglucose Distearate, Hydrogenated Lecithin, Sorbitan Stearate, Ammonium Acryloyl- dimethyltaurate/VP Copolymer, Macadamia Ternifolia Seed Oil, Carbomer, Tromethamine, Betaine, Tocopherol, Ethylhexylglycerin, Helian- thus Annuus (Sunflower) Seed Oil, Adenosine, Disodium EDTA, Cholesterol, Polyglyceryl-10 Oleate, Brassica Campestris (Rapeseed) Sterols, Phytosteryl/Behenyl/Octyldodecyl Lauroyl Glutamate, Retinal, Silica, Aluminum/Magnesium Hydroxide Stearate, Potassium Cetyl Phosphate, Pentaerythrityl Tetra-Di-T-Butyl Hydroxyhy- drocinnamate, Arctium Lappa Root Extract, Cnidium Officinale Root Extract, Dioscorea Japonica Root Extract, Paeonia Suffruticosa Root Extract, Rehmannia Chinensis Root Extract, 3-0-Ethyl Ascorbic Acid, Bakuchiol, SH-Oligopep- tide-1, SH-Oligopeptide-2, SH-Polypeptide-1
Les ingrédients peuvent changer à la discrétion du fabricant. Pour connaître la liste complète et à jour des ingrédients, veuillez vous référer au packaging.
Pays d'importation : Corée du Sud
Référence : 1126934079
Nous offrons la livraison en France, en Belgique, Luxembourg et La Suisse pour toutes les commandes. Tous les colis sont suivis pour plus de commodité et la livraison est effectuée sous 6 à 10 jours ouvrés.
Si vous n'êtes pas entièrement satisfait de votre achat, contactez-nous via le bouton d'aide ; nous vous accompagnerons pour tout échange, retour ou remboursement. Vos droits de consommateur sont protégés jusqu'à 90 jours après réception de vos produits.

FAQ

Le sérum SEOUL 1988 a été conçu pour les adultes et fonctionne particulièrement bien pour les peaux matures et qui vieillissent. Pour profiter des bienfaits anti-âge, la plupart des gens commence à utiliser le produit à la vingtaine. Si vous êtes plus jeune et songez à utiliser ce sérum pour traiter votre acné ou autres problèmes cutanés, nous vous conseillons de consulter d'abord un dermatologiste.
Le temps que cela prend pour constater des résultats visibles dépend de votre type de peau, vos problèmes cutanés et votre fréquence d'utilisation du sérum SEOUL 1988.
Certains effets, comme une hydratation cutanée accrue ou une atténuation des rougeurs, peuvent apparaître après 1 à 2 semaines. Les améliorations plus visibles du grain de peau, du teint et des signes de l'âge mettent généralement plus de temps à se manifester car la peau a besoin de temps pour se régénérer naturellement et répondre aux principes actifs du sérum.
Si le rétinal est nouveau pour vous, introduisez-le graduellement à votre routine en utilisant le sérum deux fois par semaine durant les deux premières semaines. En semaines 3 et 4, appliquez-le un soir sur deux. À partir de la cinquième semaine, vous pouvez commencer à l'appliquer tous les soirs.
Rappel : améliorer l'apparence de sa peau n'est pas un sprint, c'est un marathon. Utilisez assidument le sérum rétinal SEOUL 1988 pour transformer votre peau au fil du temps.
Oh que oui ! Le rétinal liposomé de LUMINOR SEOUL 1988 Serum n'est pas un rétinal standard. Dans cette formule, le rétinal est encapsulé dans des microcapsules sphériques appelées liposomes. Cela permet de préserver la stabilité de l'actif et d'optimiser son absorption pour réduire les risques d'irritation. Résultat : une version plus douce et efficace du rétinal offrant de remarquables bienfaits sans inconfort notable.
Oui, vous disposez de 90 jours après réception pour demander un échange ou un remboursement si vous n’êtes pas satisfaite.
Les commandes sont expédiées sous 24/48h, avec un délai de livraison moyen de 6 à 10 jours ouvrés selon votre localisation.
WE LOVE THE PLANET
RECYCLABLE PACKAGING
WE LOVE THE PLANET
RECYCLABLE PACKAGING
WE LOVE THE PLANET
RECYCLABLE PACKAGING
WE LOVE THE PLANET
RECYCLABLE PACKAGING
WE LOVE THE PLANET
RECYCLABLE PACKAGING
WE LOVE THE PLANET
RECYCLABLE PACKAGING
WE LOVE THE PLANET
RECYCLABLE PACKAGING
WE LOVE THE PLANET
RECYCLABLE PACKAGING
WE LOVE THE PLANET
RECYCLABLE PACKAGING
WE LOVE THE PLANET
RECYCLABLE PACKAGING
Shop Denim Jackets
RECYCLABLE PACKAGING
Shop Denim Jackets
RECYCLABLE PACKAGING
Shop Denim Jackets
RECYCLABLE PACKAGING
Shop Denim Jackets
RECYCLABLE PACKAGING
Shop Denim Jackets
RECYCLABLE PACKAGING
Shop Denim Jackets
RECYCLABLE PACKAGING
Shop Denim Jackets
RECYCLABLE PACKAGING
Shop Denim Jackets
RECYCLABLE PACKAGING
Shop Denim Jackets
RECYCLABLE PACKAGING
Shop Denim Jackets
RECYCLABLE PACKAGING
Entrez dans l’univers
#LUMINOR®
@luminor_cosmetics
Nourrir l'éthique sans sacrifier l'efficacité
Offrir la tranquillité d'esprit à nos clients
Assurant une absorption et une utilisation optimales par votre peau
Transparence totale sur l'origine et la qualité


Vegan
Non testé sur les animaux
Sans paraben
Vegan
Non testé sur les animaux
Sans paraben
Vegan
Non testé sur les animaux
Sans paraben
Vegan
Non testé sur les animaux
Sans paraben
Vegan
Non testé sur les animaux
Sans paraben
Vegan
Non testé sur les animaux
Sans paraben
Vegan
Non testé sur les animaux
Sans paraben
Vegan
Non testé sur les animaux
Sans paraben
Vegan
Non testé sur les animaux
Sans paraben
Vegan
Non testé sur les animaux
Sans paraben
Vegan
Non testé sur les animaux
Sans paraben
Vegan
Non testé sur les animaux
Sans paraben
Vegan
Non testé sur les animaux
Sans paraben
Vegan
Non testé sur les animaux
Sans paraben
Vegan
Non testé sur les animaux
Sans paraben
Livraison à domicile partout en France
Payez en sécurité lorsque vous commandez chez nous
Pas de questions à se poser
La satisfaction du client, priorité numéro 1
Soyez le premier à connaître les nouvelles collections et les offres exclusives.





